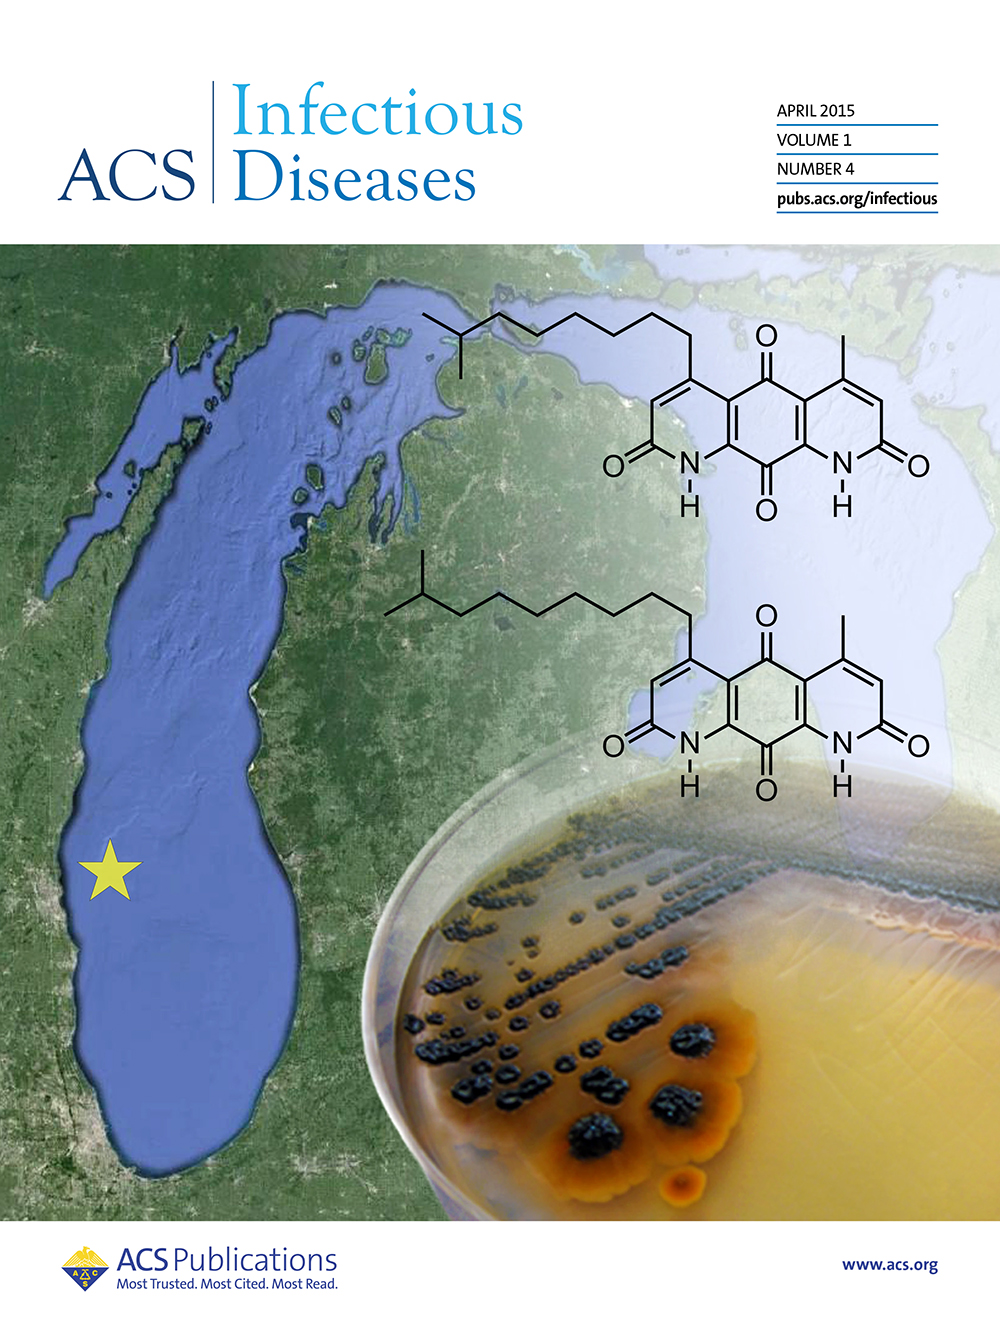

Mullowney, M. W.; Fiebig, A.; Schnizlein, M. K.; McMillin, M.; Koval, J.; Rubin, D.; Dalal, S.; Sogin, M.L.; Chang, E. B.; Sidebottom, A. M.; Crosson, S. Microbially-catalyzed conjugation of GABA and tyramine to bile acids. J. Bacteriol. 2024, 206 , e00426–23.
- NOTE: This article was featured on the cover of the journal.

Little, A. S.; Younker, I. T.; Schechter, M. S.; Bernardino, P. N.; Méheust, R.; Stemczynski, J.; Scorza, K.; Mullowney, M. W.; Sharan, D.; Waligurski, E.; Smith, R.; Ramanswamy, R.; Leiter, W.; Moran, D.; McMillin, M.; Odenwald, M. A.; Iavarone, A. T.; Sidebottom, A. M.; Sundararajan A.; Pamer E. G.; Eren A. M.; Light S. H. Dietary- and host-derived metabolites are used by diverse gut bacteria for anaerobic respiration. Nat. Microbiol. 2024, 9 , 55–69.

Mullowney, M. W.*; Duncan, K. R.*; Elsayed, S. S.*; Garg, N.*; van der Hooft, J. J. J.*; Martin, N. I.*; Meijer, D.*; Terlouw, B. R.*; Biermann, F.; Blin, K.; Durairaj, J.; González, M. G.; Helfrich, E. j. N.; Huber, F.; Leopold-Messer, S.; Rajan, K.; de Rond, T.; van Santen, J. A.; Sorokina, M.; Balunas, M. J.; Beniddir, M. A.; van Bergeijk, D. A.; Carroll, L.M.; Clark, C. M.; Clevert D. A.,; Dejong, C. A.; Du, C.; Ferrinho, S.; Grisoni, F.; Hofstetter, A.; Jespers, W.; Kalinina, O. V.; Kautsar, S. A.; Kim, H.; Leao, T. F.; Masschelein, J.; Rees, E. R.; Reher, R.; Reker, D; Schwaller, P.; Segler, M.; Skinnider, M. A.; Walker, A. S.; Willighagen, E. L.; Zdrazil, B.; Ziemert, N.; Goss, R. J. M.; Guyomard, P.; Volkamer, A.; Gerwick, W. H.; Kim, H. U.; Müller, R.; van Wezel, G. P.; van Westen, G. J. P.; Hirsch, A. K. H.; Linington, R. G.; Robinson, S. L.; Medema., M. H. Artificial intelligence for natural product drug discovery. Nat. Rev. Drug Discov. 2023, 22 , 895–916
*Joint first authors..

- Stutz, M. R.; Dylla, N. P.; Pearson, S. D.; Lecompte-Osorio, P.; Nayak, R.; Khalid; M.; Adler, E.; Boissiere, J.; Lin, H.; Leiter, W.; Little, J.; Rose, A.; Moran, D.; Mullowney, M. W.; Wolfe, K. S.; Lehmann, C.; Odenwald, M.; De La Cruz, M.; Giurcanu, M.; Pohlman, A. S.; Hall, J. B.; Chaubard, J.; Sundararajan, A.; Sidebottom, A.; Kress, J. P.; Pamer, E. G.; Patel, B. K. Immunomodulatory fecal metabolites are associated with mortality in COVID-19 patients with respiratory failure. Nat. Commun. 2022, 13 , 1–11.

- Clark, C. M.; Hernandez, A.; Mullowney, M. W.; Fitz-Henley, J.; Li, E.; Romanowski, S. B.; Pronzato, R.; Manconi, R.; Sanchez L. M.; Murphy, B.T. Relationship between bacterial phylotype and specialized metabolite production in the culturable microbiome of two freshwater sponges. ISME Commun. 2022, 2, 1-11.

- Mullowney, M.W.; Maltseva, N. I.; Endres, M.; Kim, Y.; Joachimiak, A.; Crofts, T. S. Functional and structural characterization of diverse NfsB chloramphenicol reductase enzymes from human pathogens. Microbiol. Spectr. 2022, 10, e00139-22.

- Schorn, M. A.; Verhoeven, S.; Ridder, L.; Huber, F.; Acharya, D. D.; Aksenov, A. A.; Aleti, G.; Moghaddam, J. A.; Aron, A. T.; Aziz, S.; Bauermeister, A.; Bauman, K. D.; Baunach, M.; Beemelmanns, C.; Beman, J. M.; Berlanga-Clavero, M. V.; Blacutt, A. A.; Bode, H. B.; Boullie, A.; Brejnrod, A.; Bugni, T. S.; Calteau, A.; Cao, L.; Carrión, V. J.; Castelo-Branco, R.; Chanana, S.; Chase, A. B.; Chevrette, M. G.; Costa-Lotufo, L. V.; Crawford, J. M.; Currie, C. R.; Cuypers, B.; Dang, T.; de Rond, T.; Demko, A. M.; Dittmann, E.; Du, C.; Drozd, C.; Dujardin, J.-C.; Dutton, R. J.; Edlund, A.; Fewer, D. P.; Garg, N.; Gauglitz, J. M.; Gentry, E. C.; Gerwick, L.; Glukhov, E.; Gross, H.; Gugger, M.; Guillén Matus, D. G.; Helfrich, E. J. N.; Hempel, B.-F.; Hur, J.-S.; Iorio, M.; Jensen, P. R.; Kang, K. B.; Kaysser, L.; Kelleher, N. L.; Kim, C. S.; Kim, K. H.; Koester, I.; König, G. M.; Leao, T.; Lee, S. R.; Lee, Y.-Y.; Li, X.; Little, J. C.; Maloney, K. N.; Männle, D.; Martin H, C.; McAvoy, A. C.; Metcalf, W. W.; Mohimani, H.; Molina-Santiago, C.; Moore, B. S.; Mullowney, M. W.; Muskat, M.; Nothias, L.-F.; O’Neill, E. C.; Parkinson, E. I.; Petras, D.; Piel, J.; Pierce, E. C.; Pires, K.; Reher, R.; Romero, D.; Roper, M. C.; Rust, M.; Saad, H.; Saenz, C.; Sanchez, L. M.; Sørensen, S. J.; Sosio, M.; Süssmuth, R. D.; Sweeney, D.; Tahlan, K.; Thomson, R. J.; Tobias, N. J.; Trindade-Silva, A. E.; van Wezel, G. P.; Wang, M.; Weldon, K. C.; Zhang, F.; Ziemert, N.; Duncan, K. R.; Crüsemann, M.; Rogers, S.; Dorrestein, P. C.; Medema, M. H.; van der Hooft, J. J. J. A community resource for paired genomic and metabolomic data mining. Nat. Chem. Biol. 2021, 17, 363–368.

- Hamm, P. S.; Dunlap, C. A.; Mullowney, M.W.; Caimi, N. A.; Kelleher, N. L.; Thomson, R. J.; Porras-Alfaro, A.; Northup, D. E. Streptomyces buecherae sp. nov., an actinomycete isolated from multiple bat species. Antonie Leeuwenhoek. 2020, 113, 2213–2221.

Navarro-Muñoz, J.*; Selem-Mojica, N.*; Mullowney, M.W.*; Kautsar, S.; Tryon, J.H.; Parkinson, E.; Santos, E.D.L.; Yeong, M.; Cruz-Morales, P.; Abubucker, S.; Roeters, A.; Lokhorst, W.; Fernandez-Guerra, A.; Dias Cappelini, L.T.; Goering, A.W.; Thomson, R.J.; Metcalf, W.W.; Kelleher, N.L.; Barona-Gomez, F.; Medema, M.H. A computational framework to explore large-scale biosynthetic diversity. Nat. Chem. Biol. 2020, 16, 60–68.
*Joint first authors.
- NOTE: This article was featured on the cover of the journal.
- See also: Nature Research Chemistry Community blog feature "BEHIND THE PAPER: Charting biosynthetic diversity in big data" by Marnix Medema (article graphics by me)

- Mullowney, M.W.; McClure, R.; Robey, M.; Kelleher, N.L..; Thomson, R.J. Natural products from biosynthetic assembly lines terminating in thioester reductases. Nat. Prod. Rep. 2018, 35, 847-78.
NOTE: This article was featured on the cover of the journal.

- Mullowney, M.W.; Ó hAinmhire, E.; Tanouye, U.; Burdette, J.E.; Pham, V.C.; Murphy, B.T. A Pimarane Diterpene and Cytotoxic Angucyclines from a Marine-Derived Micromonospora sp. in Vietnam’s East Sea. Mar. Drugs. 2015, 13, 5815-27.
- Mullowney, M.W.; Newsome, A.; Wan, B.; Wei, X.; Tanouye, U.; Cho, S. H.; Franzblau S.G.; Murphy, B.T. Diaza-anthracene antibiotics from a freshwater-derived actinomycete that selectively inhibit M. tuberculosis. ACS Infect. Dis. 2015, 1, 168–74.
NOTE: This article was featured on the cover of the journal.

- Mullowney, M.W.; Ó hAinmhire, E.; Shaikh, A.; Wei, X.; Tanouye, U.; Santarsiero, B.D.; Burdette, J.E.; Murphy, B.T. Diazaquinomycins E–G, novel diaza-anthracene analogs from a marine-derived Streptomyces sp. Mar. Drugs. 2014, 12, 3574-86.

- Maresh, J. J.; Crowe, S.O.; Ralko, A.; Aparece, M.D.; Murphy, C.M.; Krzeszowiec, M.; Mullowney, M.W. Facile one-pot synthesis of tetrahydroisoquinolines from amino acids via hypochlorite-mediated decarboxylation and Pictet–Spengler condensation. Tetrahedron Lett. 2014, 55, 5047-51.
PROFESSIONAL NEWSLETTER ARTICLES